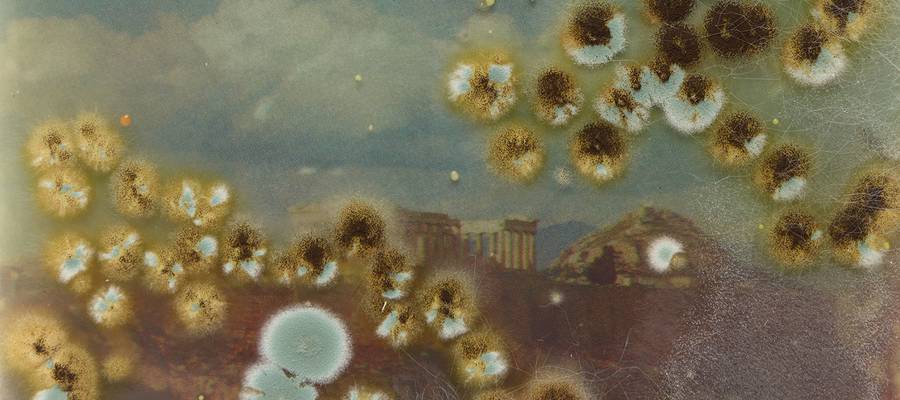
DIANA LELONEK

DIANA LELONEK
Diana Lelonek (1988) artista poloniarra da. 7th Studio of Intermedia Photography eskolan irakasle bezala ari da lanean. Dianak egiten dituen lanak Lausanneko argazki Museoan agertzen dira. Arles hirian ginenean sortu zuen Zoe-Therapy lana deskubritu dugu. Bioartean lan egiten du.

Heidegger / Bakterien eraginengatik kontaminatua /

Auguste Comte Geotrichum candidumez kutsatuta

Aristote Scedosporium apiospermumez kontaminatua
Encyclopedia of Philosophy liburutik filosofoen erretratuak hartu zituen eta galeria batean laborategi bat martxan ezarriz gero mikrobioak onddoak eta bakteriak argazkien gainean zituzten inpaktuetaz lan egin du. Dianak martxan ezarri duen Vendettak arma biologikoak baliatzen ditu.
Dianaren lana kritikoa da : "The images symbolise the actual object of the attack: the extremely complex philosophical, anthropocentric and hierarchical vision of human history, as well as the dualist concept of a world divided into the allegedly wonderfull culture and the idyllic nature."
Xehetasun gehiagorentzat :
